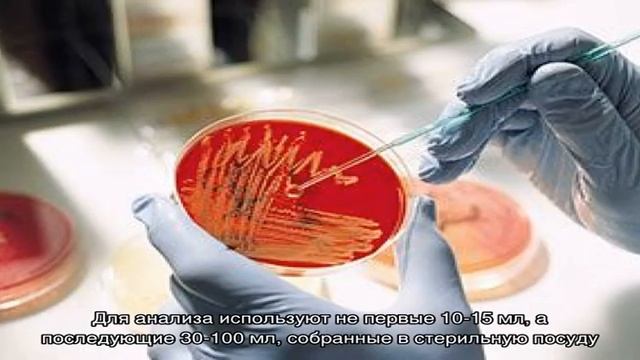
Микробиологический анализ мочи смотреть онлайн

Автор / Канал: Волшебные грибы Страница 8

Вальс облаком на уйском ковре.Урал.

Forest Farming Fungi

Майнкрафт 0121

Цветы августа 2020 года

Barudak lembur || Drama Sunda lucu| hanjakal mah Tara tihela‼️

ШОК! ПОДНЯЛИ ОГРОМНУЮ СТАЮ! КУДА СТРЕЛЯТЬ? Охота на утку с подхода осенью.

РАЗБОР книги Five nights at Freddy's Серебряные глаза

Полный обзор дачи в Каськово. Продаю новый сруб + 20 соток. 30 минут по Таллинскому шоссе.

Коровник Алла Фёдоровна

Gel de dus spumant cu zahar si merisoare, Bema Sweet Time Sugar Berry, bio, 250 ml

Идем на речку белая в Русская рыбалка 4 | рр4 | Russian Fishing 4

26 августа. Баклажаны урожай 2023.

Метеорит Челябинск 15. 02. 2013.посёлок Петровский ,Красноармейского района.

ENTHUL VS NEMO !! Wah pasti seru nih

Wrośniak anyżkowy - przyprawa z lasu? czemu nie?

Нона Копалиани -Джани Изория - Тетри Геди-1

Vladimir Peskin – Scherzo LIVE – Giuliano Sommerhalder

Moricandia arvensis

ДС 20 Оренбург Как всё начиналось

Оперативна нарада. Бровари. 7 грудня 2015 року

что за белый куб????
Микробиологический анализ мочи

В лес по сморчки. 30/4/22

Brokkoli wurde noch nie so köstlich zubereitet! Brokkoli mit Champignons in Knoblauchsoße! Lecker!
За каждым успешным каналом стоит личность, идея и сотни часов кропотливого труда. Если вы здесь, значит, автор «Волшебные грибы» уже сумел зацепить ваше внимание своим уникальным стилем или подачей. А мы на RUVIDEO позаботились о том, чтобы вы могли изучить весь архив его работ в максимально комфортных условиях — без лишней суеты и преград.
Почему за работами канала «Волшебные грибы» так интересно наблюдать? Всё просто: это честный контент, который находит отклик в сердцах зрителей. На нашем ресурсе вы можете смотреть онлайн все видео любимого автора бесплатно и в хорошем качестве. Нам важно, чтобы вы видели каждую деталь и слышали каждый нюанс, поэтому мы используем только стабильные плееры из открытых источников Rutube.
Следите за новинками канала, пересматривайте старые шедевры и открывайте для себя новые грани творчества «Волшебные грибы». Мы постоянно обновляем ленту, чтобы у вас под рукой всегда были самые свежие выпуски. Никаких сложных регистраций — только вы и творчество, которое вдохновляет. Приятного вам путешествия по миру авторского контента на RUVIDEO!
Видео взято из открытых источников Rutube. Если вы правообладатель, обратитесь к первоисточнику.